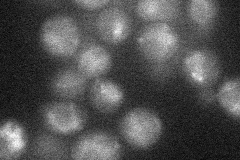
YOL105C
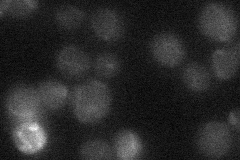
YOL105C

View description
Partially redundant sensor-transducer of the stress-activated PKC1-MPK1 signaling pathway involved in maintenance of cell wall integrity; involved in the response to heat shock and other stressors; regulates 1,3-beta-glucan synthesis
Localization:
Intensity:
Fold change:
Significance:
-
C’ GFP library in SD

below threshold17.68 -
N' NOP1pr-GFP in SD
vacuole16.2607 -
N' TEF2pr-mCherry in SD

missing0 -
N' NATIVEpr-GFP in SD
below threshold18.5583 -
N' TEF2pr-VC and Cyto-VN in SD

#N/A0 -
C’ GFP library in SD+DTT

cytosol13.530.76No -
C’ GFP library in SD+H2O2

cytosol15.330.86No -
C’ GFP library in Starvation Media

cytosol16.480.93No -
C’ GFP library on the background of Pup2-DaMP

below threshold -
C’ GFP library on the background of CCT mutant

below threshold15.08520.852651No
